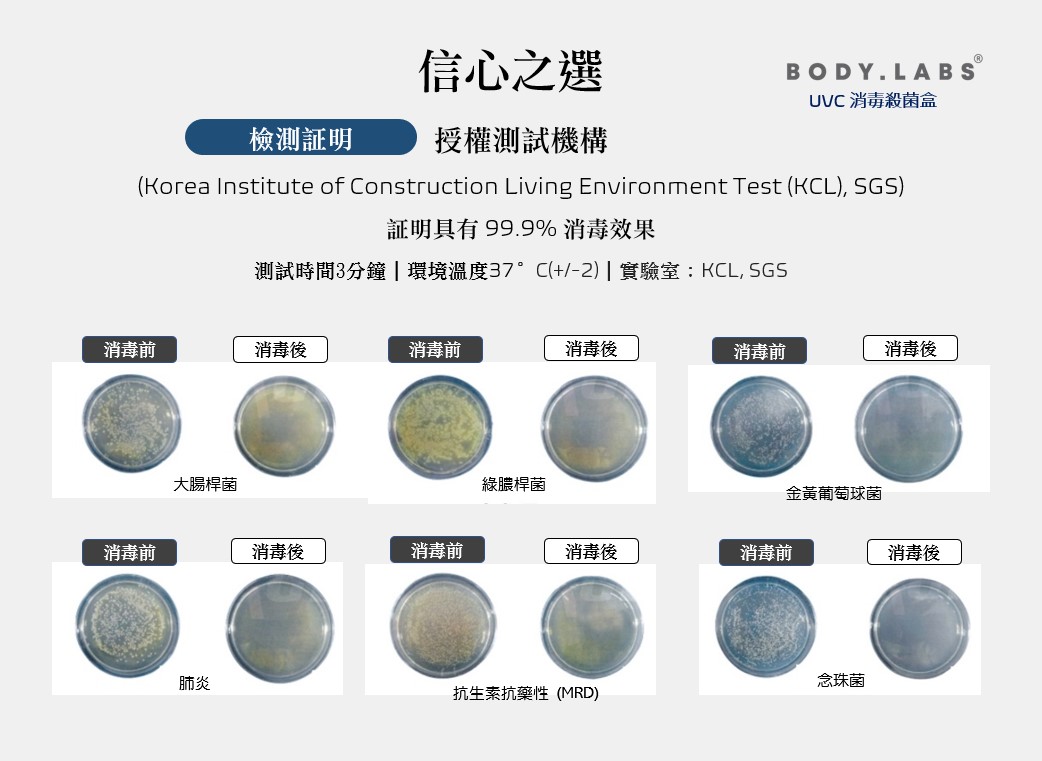

{{ 'fb_in_app_browser_popup.desc' | translate }} {{ 'fb_in_app_browser_popup.copy_link' | translate }}
{{ 'in_app_browser_popup.desc' | translate }}
{{ childProduct.title_translations | translateModel }}
{{ getChildVariationShorthand(childProduct.child_variation) }}
{{ getSelectedItemDetail(selectedChildProduct, item).childProductName }} x {{ selectedChildProduct.quantity || 1 }}
{{ getSelectedItemDetail(selectedChildProduct, item).childVariationName }}
全店,購物滿港幣$500即享免費本地派送 (2026新春福袋除外)
商品存貨不足,未能加入購物車
您所填寫的商品數量超過庫存
{{'products.quick_cart.out_of_number_hint'| translate}}
{{'product.preorder_limit.hint'| translate}}
每筆訂單限購 -1 件
{{'products.quick_cart.quantity_of_stock_hint'| translate : {message: quantityOfStock} }}
BODY LABS
韓國UVC 消毒殺菌盒
把繁瑣的消毒重任交給BODY LABS,
3分鐘消滅病菌,保障自己及家人的健康

BODY LABS UVC 消毒殺菌盒(UVC Sterilizer)功能:
產品尺寸:
21.5cm(W) x 10.2cm(L) x 6.8cm(H)
UVC – LED高效能及持久性消毒:
UV-C紫外線殺菌是利用200-280納米的光波長,以最穩定及強大的殺菌方法,對新一代各種細菌和病毒有效地殺除。
UVC – LED可使用一萬小時以上:
• 不含水銀,安全及環保
• 可使用一萬小時以上
• 快速消毒,配合繁忙都市人的生活節奏
• 有效殺滅多種細菌
• 多功能使用
光線更闊,力度更強
紫外線殺菌器只有在光線接觸到物體時才能殺菌。
BODY LABS UVC 消毒殺菌盒蓋內的8個UVC LED晶片,利用260-280納米的光波長為盒內的物件進行消毒。光線均勻接觸到物體表面,提高殺菌力。
高光反射率
內部的底面採用不銹鋼材料設計,提高了UVC光反射率。
上下重複的光能提升對物體的殺菌力,同時將光均勻地傳遞至另一面,進行無縫隙殺菌。
操作簡易,無須監控
短按圓形按鈕,消毒程序立即開始;開關產品,只須長按按鈕三秒。
消毒中LED標誌燈會畫圓並閃動;隨著消毒完畢的通知聲,LED標誌燈會停止閃爍。
變色托架,確定消毒中
產品包括一個矽樹脂托架,當托架曝露於UVC時,托架會變為淡紫色,一段時間過後會還原原色,如此便可確認殺菌性能。
當物件放於托架上,通過底部的光反射,物體下端部份都成功殺菌。
安全設備
如在消毒過程中打開產品蓋時,產品會自動立即中斷操作,直至蓋上產品蓋後才繼續未完成的消毒程序,可安心使用。
各類型隨身物件、生活用品皆適用:
手機、手錶、鑰匙、車匙、眼鏡、隱形眼鏡盒、口罩;
信用卡、八達通、門匙卡、證件;
遙控器、電腦滑鼠、文具、食具、廚房用具;
嬰兒安撫奶嘴、小玩具、毛公仔;
女士每天使用的化妝用具、項鍊、手鍊、戒指、耳飾、美甲工具等
注意事項:
• 請使用一同提供的專用充電器。(其他充電器使用時間可能縮短產品壽命或有誤操作);
• 建議在使用UVC殺菌消毒器前,充份去除物體的水氣或濕氣後使用。(如對有水氣的物品進行殺菌,可能會導致內部濕度升高,導致機器故障、滋生細菌);;
• 請在平坦的地板或枱面上使用;
• 機器使用中可能會發出類似「咔嚓」、「咔嗒」的放電聲音。這是正常現象,請放心使用;
• 請不要讓機器的光直接接觸到眼睛和皮膚上;
• 為有效強力殺菌,建議定期進行消毒盒內部清潔(請用酒精定期擦拭或用乾毛巾擦拭內部;
• 請不要將機器放置或保存於電磁設備附近;
• 請不要用濕手摸取電源插頭
產地:中國。韓國安全認證。